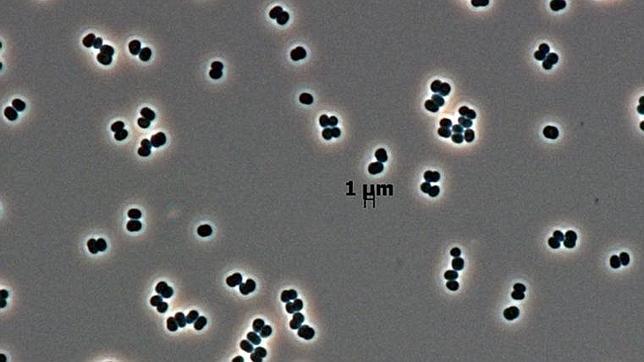
Encuentran un nuevo microorganismo en dos bases espaciales

Encuentran un nuevo microorganismo en dos bases espaciales
Sobrevive casi sin alimento en las salas esterilizadas para naves de la NASA en Florida y de la Agencia Espacial Europea en la Guayana francesa
j. de jorge
A la NASA y la Agencia Espacial Europea (ESA) no les hace falta viajar a otros planetas para encontrar curiosas formas de vida, pueden hacerlo en sus propias instalaciones. Un raro microbio , nunca antes visto, que sobrevive sin apenas ... alimento, ha sido descubierto en dos habitaciones blancas , una de la NASA en Florida y otra de la ESA en la Guayana francesa, separadas entre sí por 4.000 kilómetros. Es en estas salas esterilizadas, aisladas del exterior, donde se montan las naves espaciales. Se limpian constantemente y a conciencia para evitar contaminar de forma involuntaria otros planetas con bacterias terrestres, pero algunos microorganismos pueden resistir las condiciones más extremas.
En estas salas viven menos microbios que en cualquier otro ambiente de la Tierra. Pese a todo, unos pocos cientos resisten ante tanta higiene. «Si alguna vez encontramos vida extraterrestre, será confrontada con estos microbios», explican desde el Laboratorio de Propulsión a Chorro (JPL) de la NASA en Pasadena, California.
En efecto, el trabajo de mantener las habitaciones impolutas hace que el número total de microbios caiga en picado. Pero al mismo tiempo, esto supone una selección, ya que solo quedan aquellos que resisten condiciones tan duras como la limpieza química, los tratamientos de rayos ultravioletas y la falta de nutrientes . Y estos microbios a menudo muestran también una elevada resistencia a las metodologías de esterilización de naves espaciales, como el calentamiento y el tratamiento con peróxido. «Queremos comprender mejor cómo funcionan estos organismos, ya que las capacidades que los adaptan para sobrevivir en salas blancas también podrían permitirles sobrevivir en una nave espacial», dice Parag Vaishampayan, microbiólogo del JPL.
Forma de baya
Entre estos supervivientes existe uno particularmente raro, nunca antes visto. Se trata de una población de bacterias en forma de baya tan diferente que ha sido clasificada no solo como una nueva especie, sino también un nuevo género , el siguiente nivel de la clasificación de la diversidad de la vida. Sus descubridores la han llamado Tersicoccus phoenicis . Tersi es limpio en latín, como la sala, y Coccus, del griego, significa baya, lo que describe la forma de la bacteria. Phoenicis viene de la Phoenix Mars Lander, ya que la nave espacial estaba siendo preparada para su lanzamiento en 2007, cuando se recogió la bacteria por primera vez de suelo de una sala blanca de Florida.
Algunos otros microbios han sido descubiertos en habitaciones esterilizadas para naves espaciales, pero ningún otro antes había sido encontrado en dos salas diferentes y en ninguna otra parte. Los hogares del nuevo microbio está separados uno del otro por 4.000 kilómetros de distancia, en una instalación de la NASA en el Centro Espacial Kennedy y en un centro de la ESA en Kourou, Guayana francesa.
Una base de datos de ADN bacteriano compartida por los microbiólogos en todo el mundo llevó a Vaishampayan a darse cuenta de que ambas bacterias eran la misma. La misma base de datos global mostró que en ningún otro lugar se había detectado esta cepa. Según el investigador, esto tiene una explicación. «Descubrimos un montón de bacterias en habitaciones limpias porque trabajamos muy duro para encontrarlas. La misma bacteria puede estar en el suelo fuera de la sala, pero allí podemos no identificarla porque se oculta por una abrumadora cantidad de otras bacterias».
Una cucharadita de suelo típico tendría miles de tipos de microbios y miles de millones de microbios más que toda una sala blanca. Los microbios que son tolerantes a las condiciones duras se hacen más evidentes en entornos esterilizados que eliminan el resto de la población.
«La Tersicoccus phoenicis podría encontrarse en algún entorno natural con los niveles de nutrientes muy bajos, como una cueva o en el desierto», sospecha Vaishampayan. Este es el caso de otra especie de bacteria (Paenibacillus phoenicis) identificada por los investigadores del JPL y que actualmente se encuentra en solo dos lugares en la Tierra: una habitación blanca para naves espaciales en Florida y una mina de molibdeno a más de 2 kilómetros de profundidad en Colorado.
Encuentran un nuevo microorganismo en dos bases espaciales
Noticias relacionadas
Esta funcionalidad es sólo para suscriptores
Suscribete
Esta funcionalidad es sólo para registrados
Iniciar sesiónEsta funcionalidad es sólo para suscriptores
Suscribete